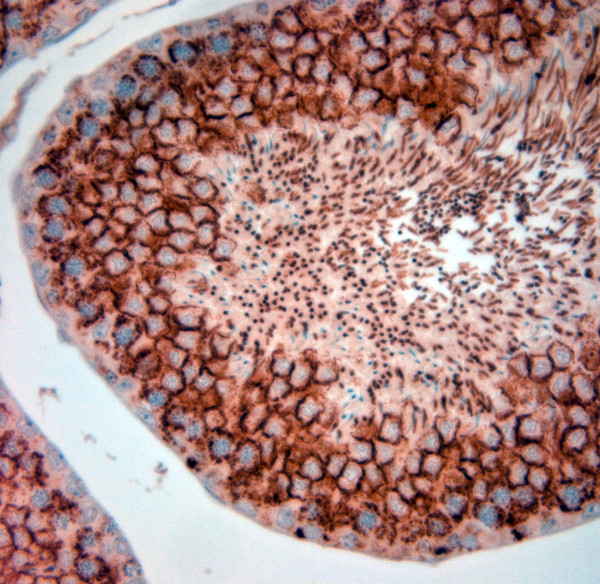
Artemin Antibody in Immunohistochemistry (Paraffin) (IHC (P))

Search
Osenses
Artemin Polyclonal Antibody
{{$productOrderCtrl.translations['antibody.pdp.commerceCard.promotion.promotions']}}
{{$productOrderCtrl.translations['antibody.pdp.commerceCard.promotion.viewpromo']}}
{{$productOrderCtrl.translations['antibody.pdp.commerceCard.promotion.promocode']}}: {{promo.promoCode}} {{promo.promoTitle}} {{promo.promoDescription}}. {{$productOrderCtrl.translations['antibody.pdp.commerceCard.promotion.learnmore']}}
图: 1 / 7
Artemin Antibody (OSA00124W-100UL) in IHC (P)







产品信息
OSA00124W-100UL
种属反应
宿主/亚型
分类
类型
抗原
偶联物
形式
浓度
保存液
内含物
保存条件
运输条件
产品详细信息
Reconstitute in 100 µL of sterile water. Centrifuge to remove any insoluble material.
Specificity of this antibody: Artemin.
靶标信息
The protein encoded by this gene is a member of the glial cell line-derived neurotophic factor (GDNF) family of ligands which are a group of ligands within the TGF-beta superfamily of signaling molecules. GDNFs are unique in having neurotrophic properties and have potential use for gene therapy in neurodegenerative disease. Artemin has been shown in culture to support the survival of a number of peripheral neuron populations and at least one population of dopaminergic CNS neurons. Its role in the PNS and CNS is further substantiated by its expression pattern in the proximity of these neurons. This protein is a ligand for the RET receptor and uses GFR-alpha 3 as a coreceptor. Multiple transcript variants encoding different isoforms have been found for this gene.
仅用于科研。不用于诊断过程。未经明确授权不得转售。
生物信息学
蛋白别名: Artemin
基因别名: Artn; neublastin
UniProt ID: (Rat) Q6AYE8, (Mouse) Q9Z0L2
Entrez Gene ID: (Rat) 362572, (Mouse) 11876